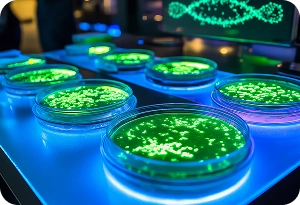
Oxford Nanopore Technology

Leveraging the Scientific Expertise in Bioinformatics
Leverage our team’s expertise in extracting insights from diverse data (biological, omics, chemical, clinical, real-world, etc.) Zifo SMEs and consultants will collaborate closely with you to develop tailored solutions, from answering scientific questions to providing dedicated teams for capability building and long-term support. Our engagement models are designed to align with your initiatives and achieve organizational goals.